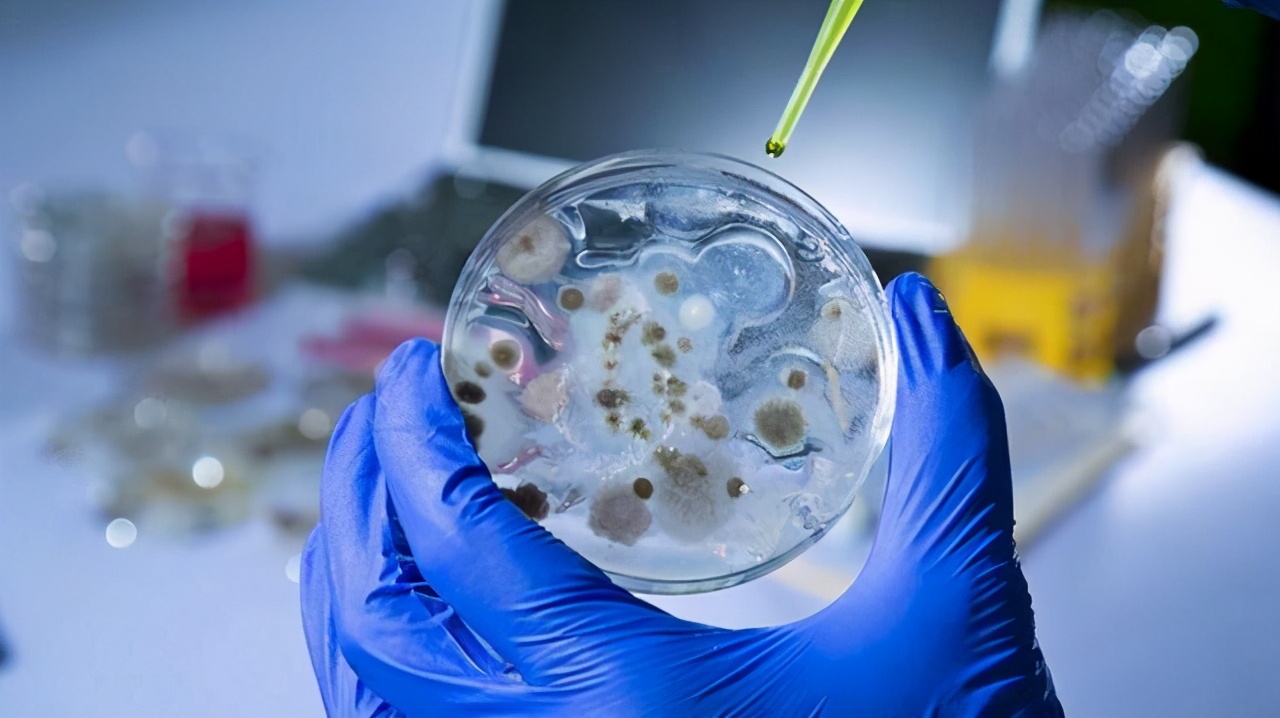
北极再现史前生物，南极爆发新冠疫情，大自然正悄悄惩罚人类

近日《当代生物学》发表了一项研究报告,报告显示,在2016年时,一名矿工在加拿大育空地区偶然发现了一名狼崽遗骸,科学家随机对其进行相关的研究以及保护。经过研究发现, 它是一只来自大约5.7万年前的狼幼崽,性别为雌性,年龄只有6-7周左右,死亡原因或为洞穴坍塌。
由于该狼崽被埋藏的位置位于永久冻土层中,常年的低温环境将狼崽遗骸保存的非常好,时隔5.7万年后,它的毛发、形态甚至表情都栩栩余生,好像是睡着了一样。

除此之外,最近媒体还报道了一则消息, 智利在南极的贝尔纳多·奥希金斯·里克尔梅基地共有36人感染新冠病毒, 其中26人是陆军人员,10人是承包商公司的平民。目前这些患者已经撤离了南极地区,并实行应有的隔离。智利陆军机构还介绍说:南极基地已经彻底消毒。

加拿大育空地区和南极出现新冠患者这两件事,看起来好像是毫无关联,但背后的机制却让人不寒而栗。
永久冻土层与冰川
其实,科学家们不止一次地在永久冻土层中发现史前遗骸,而这些遗骸的共同特征就是保存非常完整,不仅肌肉没有随着时间的流逝而腐败,就连皮肤和毛发都清晰可见。
之所以会如此,是因为 极低的温度可以使微生物分解过程暂缓甚至停止 ,以至于这些生物遗骸可以保存相当长的一段时间。

随着全球变暖,越来越多的永久冻土层开始解冻,随着人类活动,这些遗骸将会通过各种方式重现人间。比如:为了保护大象,全世界许多地方都禁止了象牙交易,然而在永久冻土层之下有许多猛犸象象牙,由于一些国家允许猛犸象牙交易,因此有许多工人在此开采猛犸象牙。

另外,科研人员为了研究古生物,也会来到这里寻找古生物遗骸,毕竟这里的古生物遗骸保存地非常完整,对于研究史前生态环境有着重要的帮助。
然而, 永久冻土层的解冻对于科学家们而言并不是什么好消息, 事实上越来越多的科学家开始担心这一现象,因为永久冻土层中埋藏的,不仅仅是古生物遗骸,还有各种微生物,包括病毒。
比特.弗雷说: 微生物具有特定的代谢和细胞结构,在低温下可以处于休眠状态,等到环境合适时它们将可能会复苏。
比如:在2016年时,西伯利亚地区的一名男孩患炭疽病死亡,而该细菌的源头竟然来自一头75年前就已经死亡的驯鹿尸体。在大多数地区,死亡75年后,遗骸会被分解的只剩骨头或者连骨头都不剩,然而在永久冻土层中,这头驯鹿的遗骸依旧保存了相当长的时间。当当地气温升高时,埋藏驯鹿的永久冻土层开始融化,这些病原体又一次进入到了生态链,最终导致了一名男孩死亡。
艾克斯马赛大学的让·米歇尔·克拉维里表示,能够感染人或动物的致病性病毒,包括过去曾引起流行病的病毒,都能够存活于多年冻土层中。而全球变暖将可能会让这些病毒重新进入到生态链中,威胁人或动物。

此次在南极地区发现新冠患者之所以令人感到担忧,就是因为一旦有病毒没有被消杀干净,那么这些病毒将可能会在南极地区保存非常长的时间,等到未来天气变暖,冰雪消融时,这些隐藏在南极地区的新冠病毒将可能会重新进入到生态链,继续威胁人类。
除了新冠病毒之外,曾经造成人类大规模死亡的1918年大流感病毒在极地地区也有存在,科学家们曾经从一具埋藏在永久冻土层中的遗骸中提取过这种病毒, 这意味着一旦全球变暖,永久冻土层消融,那么重现人间的将不仅仅只是史前生物遗骸,还有微生物们。 尽管不是所有的微生物都能够感染人类,但只要有一两种微生物能在人类中大规模流行,依旧会给人类世界带来严重的影响。

当然,全球变暖、永冻层融化还意味着海平面上升,一些地势低洼的沿海地区将会被淹没在海中。同时洋流也有可能乱套,导致农业崩溃,人类也会在这场悲剧中发生大规模动荡。
也就是说,当我们赖以为生的环境发生大规模变化时,尤其是永冻层以及冰川大规模消融时,人类也不能独善其身。为了我们能够在这座星球上继续生存,我们要做的还有很多。